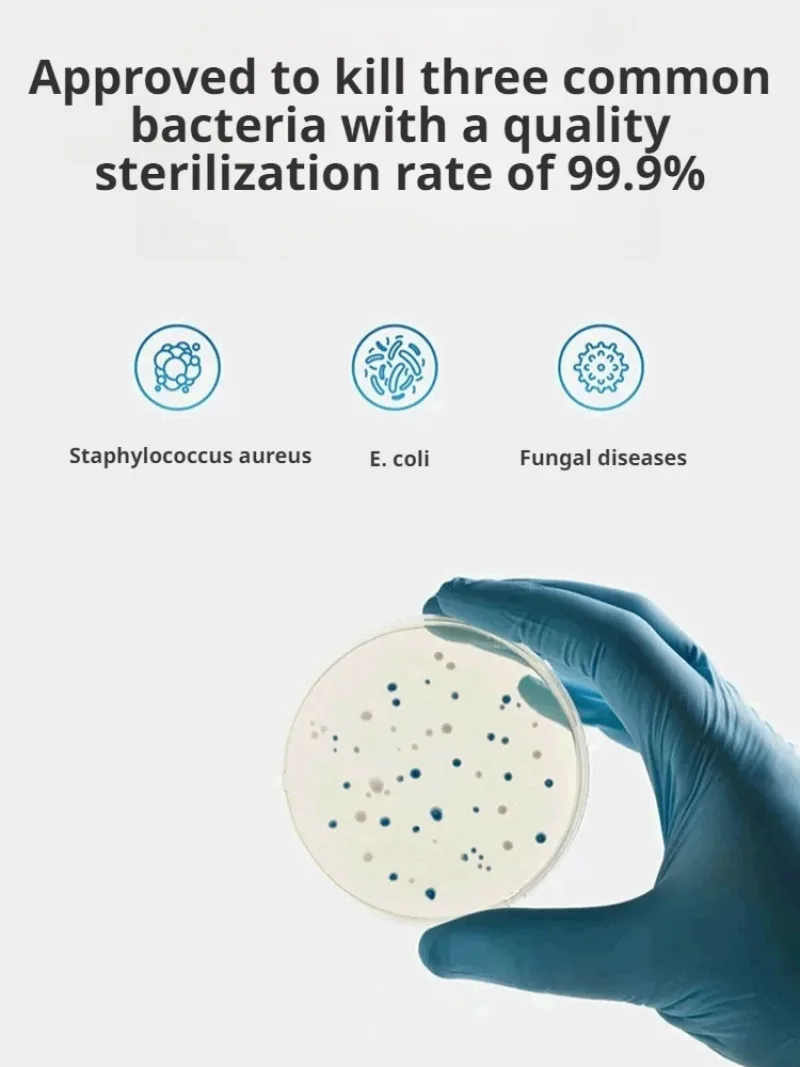

Интеллектуальный автоматический домашний робот-подметание ленивых людей должен иметь популярный робот-подметание
Price history chart & currency exchange rate
Customers also viewed

$12.68
Красный/дымчатый отражатель для заднего бампера автомобиля для BMW X5 E70 2006-2013 (без фото), 2 шт.
aliexpress.ru
$1,690.13
Автомобильный преобразователь бампера для подтяжки лица, комплект кузова для Hilux Revo Rocco, обновление для Toyota Tundra 2021, комплекты кузова
aliexpress.ru
$5.10
(2722)6 шт. 5x10 мм латунь 24K золотого цвета с цирконом бриллиантовые подвески, соединитель для браслета, высокое качество, «сделай сам», ювелирные аксессуары
aliexpress.ru
$26.57
2024 new12V Battery 9.0Ah Rechargeable Battery For Milwaukee M12 XC Cordless Tools 48-11-2402 48-11-2411 48-11-2401 MIL-12A-LI
aliexpress.ru
$12.51
25cm Palworld Plush Toy Anime Figure Palu Doll Soft Stuffed Toy Cute Pet Monster Plush Pillow Kids Toys Birthday Christmas Gifts
aliexpress.ru
$80.99
Автоматическая машинка для перманентного макияжа, вращающаяся тату-машинка с картриджем, полные инструменты для начинающих
aliexpress.ru
$44.04
Часы наручные MEGIR Мужские кварцевые, деловые водонепроницаемые спортивные с кожаным ремешком, с датой и 24-часовым циферблатом
aliexpress.ru
$16.01
Женская шаль, мягкий шейный платок, зимний теплый шейный платок, теплый шарф для шеи, вязаный шарф
joom.ru
$7.89
Чехол для шины с принтом маргариток автозапчасти водонепроницаемый и пыленепроницаемый подходит для большинства транспортных средств зап...
aliexpress.com
$226.94
europe glass ball industrial lighting chandelier ceiling ceiling decoration e27 pendant light lustre suspension moroccan decor
aliexpress.com
$8.19
Оригинальный ЖК-кабель для Lenovo ThinkPad X200 X200S X201 X201i X201S 44C9909 44C9910
aliexpress.com
$3.65
Мягкие игрушки подходят для детей и фанатов в качестве подарка для всех персонажей
aliexpress.com
$7.06
M50X Replacement Earpads Compatible With Audio Technica ATH M50 M50X M50XBT M50RD M40X M30X M20X MSR7 SX1 Headphones
aliexpress.com
$14.51
Poppy Flower Gouache Wood Grain Table Runner Country Wedding Decoration Tablecloth Home Hotel Party Kitchen Dining Table Mats
aliexpress.com
$9.29
Women Floral Print Bikini Set Sexy Ruffle Swimwear Bathing Suit New Solid Beachwear Bikinis Summer Swimsuit Female Biquini
aliexpress.com
$68.87
8" Chinese Folk Feng Shui Silver Eagle King Of Birds Head Bust Statue Sculpture R0710
aliexpress.com
$14.65
7 Column Non-Slip Hanging Wooden Abacus Chinese Soroban Educational Tool Mathmetic Calculator for Student Teacher
aliexpress.com